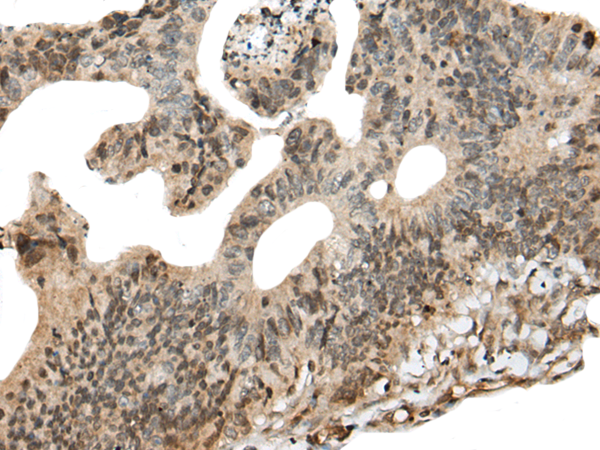

中文名稱:兔抗CALML5多克隆抗體
英文名稱: Anti-CALML5 rabbit polyclonal antibody
別 名: calmodulin like 5; CLSP
抗 原: CALML5
儲 存: 冷凍(-20℃)
宿 主: Rabbit
反應種屬: Human
標 記 物: Unconjugate
克隆類型: rabbit polyclonal
技術(shù)規(guī)格
|
Background: |
This gene encodes a novel calcium binding protein expressed in the epidermis and related to the calmodulin family of calcium binding proteins. Functional studies with recombinant protein demonstrate it does bind calcium and undergoes a conformational change when it does so. Abundant expression is detected only in reconstructed epidermis and is restricted to differentiating keratinocytes. In addition, it can associate with transglutaminase 3, shown to be a key enzyme in the terminal differentiation of keratinocytes. |
|
Applications: |
ELISA, IHC |
|
Name of antibody: |
CALML5 |
|
Immunogen: |
Full length fusion protein |
|
Full name: |
calmodulin like 5 |
|
Synonyms: |
CLSP |
|
SwissProt: |
Q9NZT1 |
|
ELISA Recommended dilution: |
5000-10000 |
|
IHC positive control: |
Human colorectal cancer and human ovarian cancer |
|
IHC Recommend dilution: |
50-300 |

購物車
幫助
021-54845833/15800441009
